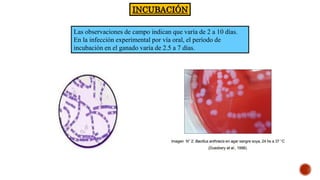
INCUBACIÓN
Las observaciones de campo indican que varía de 2 a 10 días.
En la infección experimental por vía oral, el período de
incubación en el ganado varía de 2.5 a 7 días.

Este documento proporciona información sobre el ántrax en bovinos. Resume que el ántrax es una enfermedad infecciosa bacteriana causada por Bacillus anthracis que afecta principalmente a animales adultos. Explica los síntomas agudos como fiebre, depresión y hemorragias. El diagnóstico se realiza a través de pruebas de laboratorio como cultivos e inoculación en animales. El tratamiento incluye antibióticos de alta dosis como penicilina. La prevención se logra mediante la vac